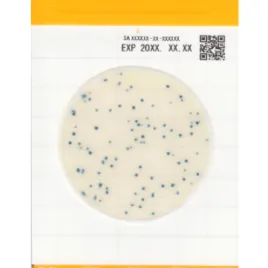

Тест-пластины Easy Plate — это удобные пластины с питательной средой, не требующие подготовки или стерилизации среды.
Easy Plate - готовы к использованию - просты в эксплуатации - надежные результаты - экономия времени - экономия места в термостате
Тест-пластины Easy Plate AC - для выявления аэробных бактерий в пищевых продуктах (КМАФАнМ)
Тест-пластины Easy Plate CC - для определения количества колиформных бактерий (БГКП)
Тест-пластины Easy Plate EC - для определения количества E.coli и колиформных бактерий в пищевых продуктах (БГКП)
Тест-пластины Easy Plate YMR - для экспресс-определения дрожжей и плесеней в пищевых продуктах и напитках за 48 часов
Тест-пластины Easy Plate SA - для экспресс-определения стафилококков в пищевых продуктах -Staphylococcus Aureus
Тест-пластины Easy Plate EB - для определения Enterobacteriaceae.
Цена носит информационный характер и ни при каких условиях не является публичной офертой. Пожалуйста, обращайтесь к специалистам нашей компании info@laboptima.ru